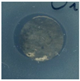
Molecules 29 04512 i040

Cu-ZnO Embedded in a Polydopamine Shell for the Generation of Antibacterial Surgical Face Masks
Abstract
1. Introduction
2. Results
2.1. Characterization of Functionalizing Agents
2.2. Characterization of Functionalized FMs
3. Discussion
4. Materials and Methods
4.1. Materials
4.2. Instruments
4.3. Syntheses of Functionalizing Agents
4.4. FMs Functionalization Procedure
4.5. Antibacterial Activity Tests
5. Conclusions
Supplementary Materials
Author Contributions
Funding
Institutional Review Board Statement
Informed Consent Statement
Data Availability Statement
Acknowledgments
Conflicts of Interest
References
- Thomas, R.E.; Thomas, B.C.; Conly, J.; Lorenzetti, D. Cleaning and Disinfecting Surfaces in Hospitals and Long-Term Care Facilities for Reducing Hospital- and Facility-Acquired Bacterial and Viral Infections: A Systematic Review. J. Hosp. Infect. 2022, 122, 9–26. [Google Scholar] [CrossRef] [PubMed]
- Ballard, D.H.; Dang, A.J.; Kumfer, B.M.; Weisensee, P.B.; Meacham, J.M.; Scott, A.R.; Ruppert-Stroescu, M.; Burke, B.A.; Morris, J.; Gan, C.; et al. Protection Levels of N95-Level Respirator Substitutes Proposed during the COVID-19 Pandemic: Safety Concerns and Quantitative Evaluation Procedures. BMJ Open 2021, 11, 45557–45566. [Google Scholar] [CrossRef]
- Spennemann, D.H.R. COVID-19 Face Masks as a Long-Term Source of Microplastics in Recycled Urban Green Waste. Sustainability 2021, 14, 207. [Google Scholar] [CrossRef]
- Tcharkhtchi, A.; Abbasnezhad, N.; Zarbini Seydani, M.; Zirak, N.; Farzaneh, S.; Shirinbayan, M. An Overview of Filtration Efficiency through the Masks: Mechanisms of the Aerosols Penetration. Bioact. Mater. 2021, 6, 106–122. [Google Scholar] [CrossRef] [PubMed]
- Asadi, S.; Cappa, C.D.; Barreda, S.; Wexler, A.S.; Bouvier, N.M.; Ristenpart, W.D. Efficacy of Masks and Face Coverings in Controlling Outward Aerosol Particle Emission from Expiratory Activities. Sci. Rep. 2020, 10, 15665. [Google Scholar] [CrossRef] [PubMed]
- Seidi, F.; Deng, C.; Zhong, Y.; Liu, Y.; Huang, Y.; Li, C.; Xiao, H. Functionalized Masks: Powerful Materials against COVID-19 and Future Pandemics. Small 2021, 17, 2102453. [Google Scholar] [CrossRef]
- De-la-Torre, G.E.; Aragaw, T.A. What We Need to Know about PPE Associated with the COVID-19 Pandemic in the Marine Environment. Mar. Pollut. Bull. 2021, 163, 111879. [Google Scholar] [CrossRef]
- Mohanty, M.; Mohanty, J.; Dey, S.; Dutta, K.; Shah, M.P.; Das, A.P. The Face Mask: A Tale from Protection to Pollution and Demanding Sustainable Solution. Emerg. Contam. 2024, 10, 100298–100310. [Google Scholar] [CrossRef]
- Li, B.; Huang, Y.; Guo, D.; Liu, Y.; Liu, Z.; Han, J.; Zhao, J.; Zhu, X.; Huang, Y.; Wang, Z.; et al. Environmental Risks of Disposable Face Masks during the Pandemic of COVID-19: Challenges and Management. Sci. Total Environ. 2022, 825, 153880. [Google Scholar] [CrossRef]
- Hui Li, A.S.; Sathishkumar, P.; Selahuddeen, M.L.; Asyraf Wan Mahmood, W.M.; Zainal Abidin, M.H.; Wahab, R.A.; Mohamed Huri, M.A.; Abdullah, F. Adverse Environmental Effects of Disposable Face Masks Due to the Excess Usage. Environ. Pollut. 2022, 308, 119674–119680. [Google Scholar] [CrossRef]
- Saliu, F.; Veronelli, M.; Raguso, C.; Barana, D.; Galli, P.; Lasagni, M. The Release Process of Microfibers: From Surgical Face Masks into the Marine Environment. Environ. Adv. 2021, 4, 100042–100053. [Google Scholar] [CrossRef]
- Hu, F.; Zhao, H.; Ding, J.; Jing, C.; Zhang, W.; Chen, X. Uptake and Toxicity of Micro-/Nanoplastics Derived from Naturally Weathered Disposable Face Masks in Developing Zebrafish: Impact of COVID-19 Pandemic on Aquatic Life. Environ. Pollut. 2024, 343, 123129–123140. [Google Scholar] [CrossRef] [PubMed]
- Aragaw, T.A.; Mekonnen, B.A. Current Plastics Pollution Threats Due to COVID-19 and Its Possible Mitigation Techniques: A Waste-to-Energy Conversion via Pyrolysis. Environ. Syst. Res. 2021, 10, 8–18. [Google Scholar] [CrossRef] [PubMed]
- Lyu, L.; Peng, H.; An, C.; Sun, H.; Yang, X.; Bi, H. An Insight into the Benefits of Substituting Polypropylene with Biodegradable Polylactic Acid Face Masks for Combating Environmental Emissions. Sci. Total Environ. 2023, 905, 167137–167148. [Google Scholar] [CrossRef]
- Selvaranjan, K.; Navaratnam, S.; Rajeev, P.; Ravintherakumaran, N. Environmental Challenges Induced by Extensive Use of Face Masks during COVID-19: A Review and Potential Solutions. Environ. Chall. 2021, 3, 100039. [Google Scholar] [CrossRef]
- Morone, P.; Yilan, G.; Imbert, E.; Becchetti, L. Reconciling Human Health with the Environment While Struggling against the COVID-19 Pandemic through Improved Face Mask Eco-Design. Sci. Rep. 2022, 12, 2445. [Google Scholar] [CrossRef]
- Dat, N.M.; Huong, L.M.; Tinh, N.T.; Linh, N.T.T.; Hai, N.D.; Viet, N.D.; Thinh, D.B.; Cong, C.Q.; Dat, N.T.; Phong, M.T.; et al. Surface Modification of Poly(Propylene) Fabric with Graphene Oxide-based Silver Nanoparticles for Antibacterial Applications. J. Appl. Polym. Sci. 2022, 139, e53119. [Google Scholar] [CrossRef]
- Abazari, M.; Badeleh, S.M.; Khaleghi, F.; Saeedi, M.; Haghi, F. Fabrication of Silver Nanoparticles-Deposited Fabrics as a Potential Candidate for the Development of Reusable Facemasks and Evaluation of Their Performance. Sci. Rep. 2023, 13, 1593. [Google Scholar] [CrossRef]
- Hiragond, C.B.; Kshirsagar, A.S.; Dhapte, V.V.; Khanna, T.; Joshi, P.; More, P.V. Enhanced Anti-Microbial Response of Commercial Face Mask Using Colloidal Silver Nanoparticles. Vacuum 2018, 156, 475–482. [Google Scholar] [CrossRef]
- Ferrari, I.V.; Giuntoli, G.; Pisani, A.; Cavallo, A.; Mazzetti, P.; Fonnesu, R.; Rosellini, A.; Pistello, M.; Al Kayal, T.; Cataldo, A.; et al. One-Step Silver Coating of Polypropylene Surgical Mask with Antibacterial and Antiviral Properties. Heliyon 2024, 10, e23196. [Google Scholar] [CrossRef]
- Ivanauskas, R.; Bronusiene, A.; Ivanauskas, A.; Šarkinas, A.; Ancutiene, I. Antibacterial Activity of Copper Particles Embedded in Knitted Fabrics. Materials 2022, 15, 7147. [Google Scholar] [CrossRef] [PubMed]
- Kumar, A.; Sharma, A.; Chen, Y.; Jones, M.M.; Vanyo, S.T.; Li, C.; Visser, M.B.; Mahajan, S.D.; Sharma, R.K.; Swihart, M.T. Copper@ZIF-8 Core-Shell Nanowires for Reusable Antimicrobial Face Masks. Adv. Funct. Mater. 2021, 31, 2008054. [Google Scholar] [CrossRef] [PubMed]
- Bolaina-Lorenzo, E.; Puente-Urbina, B.A.; Espinosa-Neira, R.; Ledezma, A.; Rodríguez-Fernández, O.; Betancourt-Galindo, R. A Simple Method to Improve Antibacterial Properties in Commercial Face Masks via Incorporation of ZnO and CuO Nanoparticles through Chitosan Matrix. Mater. Chem. Phys. 2022, 287, 126299. [Google Scholar] [CrossRef]
- Kim, M.J.; Song, Z.; Lee, C.K.; Yun, T.G.; Noh, J.Y.; Park, M.K.; Yong, D.; Kang, M.J.; Pyun, J.C. Breathing-Driven Self-Powered Pyroelectric ZnO Integrated Face Mask for Bioprotection. Small 2023, 19, 2200712. [Google Scholar] [CrossRef]
- Bahun, M.; Jukić, M.; Oblak, D.; Kranjc, L.; Bajc, G.; Butala, M.; Bozovičar, K.; Bratkovič, T.; Podlipnik, Č.; Poklar Ulrih, N. Inhibition of the SARS-CoV-2 3CLpro Main Protease by Plant Polyphenols. Food Chem. 2022, 373, 131594. [Google Scholar] [CrossRef]
- Wei, Y.; Wang, J.; Wu, S.; Zhou, R.; Zhang, K.; Zhang, Z.; Liu, J.; Qin, S.; Shi, J. Nanomaterial-Based Zinc Ion Interference Therapy to Combat Bacterial Infections. Front. Immunol. 2022, 13, 899992. [Google Scholar] [CrossRef]
- Perelshtein, I.; Lipovsky, A.; Perkas, N.; Tzanov, T.; Arguirova, M.; Leseva, M.; Gedanken, A. Ultrasonics Sonochemistry Making the Hospital a Safer Place by Sonochemical Coating of All Its Textiles with Antibacterial Nanoparticles. Ultrason. Sonochem. 2015, 25, 82–88. [Google Scholar] [CrossRef]
- Maruthapandi, M.; Saravanan, A.; Das, P.; Natan, M.; Jacobi, G.; Banin, E.; Luong, J.H.T.; Gedanken, A. Antimicrobial Activities of Zn-Doped CuO Microparticles Decorated on Polydopamine against Sensitive and Antibiotic-Resistant Bacteria. ACS Appl. Polym. Mater. 2020, 2, 5878–5888. [Google Scholar] [CrossRef]
- Raghunath, A.; Perumal, E. International Journal of Antimicrobial Agents Metal Oxide Nanoparticles as Antimicrobial Agents: A Promise for the Future. Int. J. Antimicrob. Agents 2017, 49, 137–152. [Google Scholar] [CrossRef]
- Slavin, Y.N.; Asnis, J.; Häfeli, U.O.; Bach, H. Metal Nanoparticles: Understanding the Mechanisms behind Antibacterial Activity. J. Nanobiotechnol. 2017, 15, 65. [Google Scholar] [CrossRef]
- Xavier, N.D.D.; Nandan, S.B.; Jayachandran, P.R.; Anu, P.R.; Midhun, A.M.; Mohan, D. Chronic e Ff Ects of Copper and Zinc on the Fi Sh, Etroplus Suratensis (Bloch, 1790) by Continuous Fl Ow through (CFT) Bioassay. Mar. Environ. Res. 2019, 143, 141–157. [Google Scholar] [CrossRef] [PubMed]
- He, J.; Ma, S.; Liu, L.; Liu, C.; Dong, S. A Comparison Study of Test Organism Species and Methodologies for Combined Toxicity Assay of Copper Ions and Zinc Ions. Environ. Sci. Pollut. Res. 2020, 27, 45992–46002. [Google Scholar] [CrossRef] [PubMed]
- Nikolova, M.P.; Chavali, M.S. Metal Oxide Nanoparticles as Biomedical Materials. Biomimetics 2020, 5, 27. [Google Scholar] [CrossRef] [PubMed]
- Bengalli, R.; Colantuoni, A.; Perelshtein, I.; Gedanken, A.; Collini, M.; Mantecca, P.; Fiandra, L. In Vitro Skin Toxicity of CuO and ZnO Nanoparticles: Application in the Safety Assessment of Antimicrobial Coated Textiles. NanoImpact 2021, 21, 100282–100292. [Google Scholar] [CrossRef] [PubMed]
- Rahman, H.S.; Othman, H.H.; Abdullah, R.; Edin, H.Y.A.S.; AL-Haj, N.A. Beneficial and Toxicological Aspects of Zinc Oxide Nanoparticles in Animals. Vet. Med. Sci. 2022, 8, 1769–1779. [Google Scholar] [CrossRef]
- Naz, S.; Gul, A.; Zia, M. Toxicity of Copper Oxide Nanoparticles: A Review Study. IET Nanobiotechnol. 2020, 14, 1–13. [Google Scholar] [CrossRef]
- Costa, S.M.; Pacheco, L.; Antunes, W.; Vieira, R.; Bem, N.; Teixeira, P.; Fangueiro, R.; Ferreira, D.P. Antibacterial and Biodegradable Electrospun Filtering Membranes for Facemasks: An Attempt to Reduce Disposable Masks Use. Appl. Sci. 2021, 12, 67. [Google Scholar] [CrossRef]
- Guo, S.; Yu, B.; Ahmed, A.; Cong, H.; Shen, Y. Synthesis of Polyacrylonitrile/Polytetrahydropyrimidine (PAN/PTHP) Nanofibers with Enhanced Antibacterial and Anti-Viral Activities for Personal Protective Equipment. J. Hazard. Mater. 2022, 424, 127602–127612. [Google Scholar] [CrossRef]
- Karagoz, S.; Burak Kiremitler, N.; Sarp, G.; Pekdemir, S.; Salem, S.; Goksu, A.G.; Serdar Onses, M.; Sozdutmaz, I.; Sahmetlioglu, E.; Ozkara, E.S.; et al. Antibacterial, Antiviral, and Self-Cleaning Mats with Sensing Capabilities Based on Electrospun Nanofibers Decorated with ZnO Nanorods and Ag Nanoparticles for Protective Clothing Applications. ACS Appl. Mater. Interfaces 2021, 13, 5678–5690. [Google Scholar] [CrossRef]
- Blosi, M.; Costa, A.L.; Ortelli, S.; Belosi, F.; Ravegnani, F.; Varesano, A.; Tonetti, C.; Zanoni, I.; Vineis, C. Polyvinyl Alcohol/Silver Electrospun Nanofibers: Biocidal Filter Media Capturing Virus-Size Particles. J. Appl. Polym. Sci. 2021, 138, 51380. [Google Scholar] [CrossRef]
- Cano-Vicent, A.; Tuñón-Molina, A.; Martí, M.; Muramoto, Y.; Noda, T.; Takayama, K.; Serrano-Aroca, Á. Antiviral Face Mask Functionalized with Solidified Hand Soap: Low-Cost Infection Prevention Clothing against Enveloped Viruses Such as SARS-CoV-2. ACS Omega 2021, 6, 23495–23503. [Google Scholar] [CrossRef] [PubMed]
- Gonzalez, A.; Aboubakr, H.A.; Brockgreitens, J.; Hao, W.; Wang, Y.; Goyal, S.M.; Abbas, A. Durable Nanocomposite Face Masks with High Particulate Filtration and Rapid Inactivation of Coronaviruses. Sci. Rep. 2021, 11, 24318. [Google Scholar] [CrossRef] [PubMed]
- Hu, W.; Lu, S.; Ma, Y.; Ren, P.; Ma, X.; Zhou, N.; Zhang, T.; Ji, Z. Poly(Dopamine)-Inspired Surface Functionalization of Polypropylene Tissue Mesh for Prevention of Intra-Peritoneal Adhesion Formation. J. Mater. Chem. B 2017, 5, 575–585. [Google Scholar] [CrossRef] [PubMed]
- Ojstršek, A.; Chemelli, A.; Osmić, A.; Gorgieva, S. Dopamine-Assisted Modification of Polypropylene Film to Attain Hydrophilic Mineral-Rich Surfaces. Polymers 2023, 15, 902. [Google Scholar] [CrossRef]
- Kafkopoulos, G.; Padberg, C.J.; Duvigneau, J.; Vancso, G.J. Adhesion Engineering in Polymer-Metal Comolded Joints with Biomimetic Polydopamine. ACS Appl. Mater. Interfaces 2021, 13, 19244–19253. [Google Scholar] [CrossRef]
- Tang, Z.; Miao, Y.; Zhao, J.; Xiao, H.; Zhang, M.; Liu, K.; Zhang, X.; Huang, L.; Chen, L.; Wu, H. Mussel-Inspired Biocompatible Polydopamine/Carboxymethyl Cellulose/Polyacrylic Acid Adhesive Hydrogels with UV-Shielding Capacity. Cellulose 2021, 28, 1527–1540. [Google Scholar] [CrossRef]
- Qie, R.; Zajforoushan Moghaddam, S.; Thormann, E. Dopamine-Assisted Layer-by-Layer Deposition Providing Coatings with Controlled Thickness, Roughness, and Functional Properties. ACS Omega 2023, 8, 2965–2972. [Google Scholar] [CrossRef]
- Feinberg, H.; Hanks, T.W. Polydopamine: A Bioinspired Adhesive and Surface Modification Platform. Polym. Int. 2022, 71, 578–582. [Google Scholar] [CrossRef]
- British Standards Institute. Textile Fabrics—Determination of Antibacterial Activity—Agar Diffusion Plate Test; British Standards Institute: London, UK, 2004. [Google Scholar]
- Dreyer, D.R.; Miller, D.J.; Freeman, B.D.; Paul, D.R.; Bielawski, C.W. Elucidating the Structure of Poly(Dopamine). Langmuir 2012, 28, 6428–6435. [Google Scholar] [CrossRef]
- Yang, H.C.; Luo, J.; Lv, Y.; Shen, P.; Xu, Z.K. Surface Engineering of Polymer Membranes via Mussel-Inspired Chemistry. J. Membr. Sci. 2015, 483, 42–59. [Google Scholar] [CrossRef]
- Bogush, A.A.; Kourtchev, I. Disposable Surgical/Medical Face Masks and Filtering Face Pieces: Source of Microplastics and Chemical Additives in the Environment. Environ. Pollut. 2024, 348, 123792–123801. [Google Scholar] [CrossRef] [PubMed]
- Kaur, M.; Ghosh, D.; Guleria, S.; Arya, S.K.; Puri, S.; Khatri, M. Microplastics/Nanoplastics Released from Facemasks as Contaminants of Emerging Concern. Mar. Pollut. Bull. 2023, 191, 114954. [Google Scholar] [CrossRef] [PubMed]
- Si, Y.; Zhang, X.; Liang, T.; Xu, X.; Qiu, L.; Li, P.; Duo, S. Facile In-Situ Synthesis of 2D/3D g-C3N4/Cu2O Heterojunction for High-Performance Photocatalytic Dye Degradation. Mater. Res. Express 2020, 7, 015524. [Google Scholar] [CrossRef]
- Goutam, S.P.; Kumar Yadav, A.; Das, A.J. Coriander Extract Mediated Green Synthesis of Zinc Oxide Nanoparticles and Their Structural, Optical and Antibacterial Properties. Share Your Innov. JACS Dir. J. Nanosci. Technol. Visit. J. 2017, 3, 249–252. [Google Scholar]
- Prabhu, T.; Taraka, Y.; Gautam, A.; Lata, S.; Bojja, S. Controlled Addition of Cu/Zn in Hierarchical CuO/ZnO p-n Heterojunction Photocatalyst for High Photoreduction of CO2 to MeOH. J. CO2 Util. 2019, 31, 207–214. [Google Scholar] [CrossRef]
- Ahmad, T.; Pandey, V.; Husain, M.S.; Adiba; Munjal, S. Structural and Spectroscopic Analysis of Pure Phase Hexagonal Wurtzite ZnO Nanoparticles Synthesized by Sol-Gel. Mater. Today Proc. 2021, 49, 1694–1697. [Google Scholar] [CrossRef]
- Manzoor, U.; Siddique, S.; Ahmed, R.; Noreen, Z.; Bokhari, H.; Ahmad, I. Antibacterial, Structural and Optical Characterization of Mechano-Chemically Prepared ZnO Nanoparticles. PLoS ONE 2016, 11, e0154704. [Google Scholar] [CrossRef]
- Gleißner, R.; Chung, S.; Semione, G.D.L.; Jacobse, L.; Wagstaffe, M.; Tober, S.; Neumann, A.J.; Gizer, G.; Goodwin, C.M.; Soldemo, M.; et al. Role of Oxidation–Reduction Dynamics in the Application of Cu/ZnO-Based Catalysts. ACS Appl. Nano Mater. 2023, 6, 8004–8016. [Google Scholar] [CrossRef]
- Wang, T.; Zhang, Q.; Li, J.; Xu, G.; Guo, N.; Song, P.; Xia, L. Polydopamine-Assisted In Situ Growth of AgNPs on Face Masks for the Detection of Pesticide Based on Surface-Enhanced Raman Scattering Spectroscopy. Plasmonics 2022, 17, 1743–1750. [Google Scholar] [CrossRef]
- Yang, J.; Xu, H.; Zhang, L.; Zhong, Y.; Sui, X.; Mao, Z. Lasting Superhydrophobicity and Antibacterial Activity of Cu Nanoparticles Immobilized on the Surface of Dopamine Modified Cotton Fabrics. Surf. Coat. Technol. 2017, 309, 149–154. [Google Scholar] [CrossRef]
- Siciliano, G.; Monteduro, A.G.; Turco, A.; Primiceri, E.; Rizzato, S.; Depalo, N.; Curri, M.L.; Maruccio, G. Polydopamine-Coated Magnetic Iron Oxide Nanoparticles: From Design to Applications. Nanomaterials 2022, 12, 1145. [Google Scholar] [CrossRef] [PubMed]
- Yang, Y.; Li, Y.; Zhai, W.; Li, X.; Li, D.; Lin, H.; Han, S. Electrokinetic Preseparation and Molecularly Imprinted Trapping for Highly Selective SERS Detection of Charged Phthalate Plasticizers. Anal. Chem. 2021, 93, 946–955. [Google Scholar] [CrossRef] [PubMed]
- Vu, T.H.; Nguyen, P.T.; Kim, M. Il Polydopamine-Coated Co3O4 Nanoparticles as an Efficient Catalase Mimic for Fluorescent Detection of Sulfide Ion. Biosensors 2022, 12, 1047. [Google Scholar] [CrossRef] [PubMed]
- Yan, S.; Stackhouse, C.A.; Waluyo, I.; Hunt, A.; Kisslinger, K.; Head, A.R.; Bock, D.C.; Takeuchi, E.S.; Takeuchi, K.J.; Wang, L.; et al. Reusing Face Covering Masks: Probing the Impact of Heat Treatment. ACS Sustain. Chem. Eng. 2021, 9, 13545–13558. [Google Scholar] [CrossRef]
- Ariyoshi, S.; Hashimoto, S.; Ohnishi, S.; Negishi, S.; Mikami, H.; Hayashi, K.; Tanaka, S.; Hiroshiba, N. Materials Science & Engineering B Broadband Terahertz Spectroscopy of Cellulose Nanofiber-Reinforced Polypropylenes. Mater. Sci. Eng. B 2021, 265, 115000. [Google Scholar] [CrossRef]
- Caban, R. FTIR-ATR Spectroscopic, Thermal and Microstructural Studies on Polypropylene-Glass Fiber Composites. J. Mol. Struct. 2022, 1264, 133181–133188. [Google Scholar] [CrossRef]
- Fang, J.; Zhang, L.; Sutton, D.; Wang, X.; Lin, T. Needleless Melt-Electrospinning of Polypropylene Nanofibres. J. Nanomater. 2012, 2012, 382639. [Google Scholar] [CrossRef]
- Ho, W.C.J.; Tay, Q.; Qi, H.; Huang, Z.; Li, J.; Chen, Z. Photocatalytic and Adsorption Performances of Faceted Cuprous Oxide (Cu2O) Particles for the Removal of Methyl Orange (MO) from Aqueous Media. Molecules 2017, 22, 677. [Google Scholar] [CrossRef]
- Kader, D.A.; Rashid, S.O.; Omer, K.M. Green Nanocomposite: Fabrication, Characterization, and Photocatalytic Application of Vitamin C Adduct-Conjugated ZnO Nanoparticles. RSC Adv. 2023, 13, 9963–9977. [Google Scholar] [CrossRef]
- Shafiey Dehaj, M.; Zamani Mohiabadi, M. Experimental Study of Water-Based CuO Nanofluid Flow in Heat Pipe Solar Collector. J. Therm. Anal. Calorim. 2019, 137, 2061–2072. [Google Scholar] [CrossRef]
- Rahoui, N.; Hegazy, M.; Jiang, B.; Taloub, N.; Huang, Y.D. Particles Size Estimation of Polydopamine Based Polymeric Nanoparticles Using Near-Infrared Spectroscopy Combined with Linear Regression Method. Am. J. Anal. Chem. 2018, 09, 273–285. [Google Scholar] [CrossRef]
- Natsathaporn, P.; Herwig, G.; Altenried, S.; Ren, Q.; Rossi, R.M.; Crespy, D.; Itel, F. Functional Fiber Membranes with Antibacterial Properties for Face Masks. Adv. Fiber Mater. 2023, 5, 1519–1533. [Google Scholar] [CrossRef] [PubMed]
- Kasbe, P.S.; Gade, H.; Liu, S.; Chase, G.G.; Xu, W. Ultrathin Polydopamine-Graphene Oxide Hybrid Coatings on Polymer Filters with Improved Filtration Performance and Functionalities. ACS Appl. Bio Mater. 2021, 4, 5180–5188. [Google Scholar] [CrossRef] [PubMed]
- International Standard ISO. 20645:2004 Textile Fabrics—Determination of Antibacterial Activity—Agar Diffusion Plate Test, 1st ed.; International Organization for Standardization: Geneva, Switzerland, 2004; pp. 1–9. [Google Scholar]
- Pinho, E.; Magalhães, L.; Henriques, M.; Oliveira, R. Antimicrobial Activity Assessment of Textiles: Standard Methods Comparison. Ann. Microbiol. 2011, 61, 493–498. [Google Scholar] [CrossRef]
- Wang, Z.; Zou, Y.; Li, Y.; Cheng, Y. Metal-Containing Polydopamine Nanomaterials: Catalysis, Energy, and Theranostics. Small 2020, 16, 1907042. [Google Scholar] [CrossRef]
- Fang, Q.; Zhang, J.; Bai, L.; Duan, J.; Xu, H.; Cham-Fai Leung, K.; Xuan, S. In Situ Redox-Oxidation Polymerization for Magnetic Core-Shell Nanostructure with Polydopamine-Encapsulated-Au Hybrid Shell. J. Hazard. Mater. 2019, 367, 15–25. [Google Scholar] [CrossRef]
- Huang, Q.; Chen, J.; Liu, M.; Huang, H.; Zhang, X.; Wei, Y. Polydopamine-Based Functional Materials and Their Applications in Energy, Environmental, and Catalytic Fields: State-of-the-Art Review. Chem. Eng. J. 2020, 387, 124019–124034. [Google Scholar] [CrossRef]
- Shalev, T.; Gopin, A.; Bauer, M.; Stark, R.W.; Rahimipour, S. Non-Leaching Antimicrobial Surfaces through Polydopamine Bio-Inspired Coating of Quaternary Ammonium Salts or an Ultrashort Antimicrobial Lipopeptide. J. Mater. Chem. 2012, 22, 2026–2032. [Google Scholar] [CrossRef]
- Ding, Y.H.; Floren, M.; Tan, W. Mussel-Inspired Polydopamine for Bio-Surface Functionalization. Biosurface Biotribol. 2016, 2, 121–136. [Google Scholar] [CrossRef]
- Liu, X.; Cao, J.; Li, H.; Li, J.; Jin, Q.; Ren, K.; Ji, J. Mussel-Inspired Polydopamine: A Biocompatible and Ultrastable Coating for Nanoparticles in Vivo. ACS Nano 2013, 7, 9384–9395. [Google Scholar] [CrossRef]
- Qiu, W.Z.; Yang, H.C.; Xu, Z.K. Dopamine-Assisted Co-Deposition: An Emerging and Promising Strategy for Surface Modification. Adv. Colloid Interface Sci. 2018, 256, 111–125. [Google Scholar] [CrossRef] [PubMed]
- Postma, A.; Yan, Y.; Wang, Y.; Zelikin, A.N.; Tjipto, E.; Caruso, F. Self-Polymerization of Dopamine as a Versatile and Robust Technique to Prepare Polymer Capsules. Chem. Mater. 2009, 21, 3042–3044. [Google Scholar] [CrossRef]
- Tian, N.; Xu, D.; Wei, J.; Li, B.; Zhang, J. Long-Lasting Anti-Bacterial Face Masks Enabled by Combining Anti-Bacterial Materials and Superhydrophobic Coating. Surf. Coat. Technol. 2024, 476, 130229–130236. [Google Scholar] [CrossRef]
- Mattone, M.; Rescic, S.; Fratini, F.; Del Fà, R.M. Experimentation of Earth-Gypsum Plasters for the Conservation of Earthen Constructions. Int. J. Archit. Herit. 2017, 11, 763–772. [Google Scholar] [CrossRef]
- Chen, N.-F.; Liao, Y.-H.; Lin, P.-Y.; Chen, W.-F.; Wen, Z.-H.; Hsieh, S. Investigation of the Characteristics and Antibacterial Activity of Polymer-Modified Copper Oxide Nanoparticles. Int. J. Mol. Sci. 2021, 22, 12913. [Google Scholar] [CrossRef]
- Ho, C.C.; Ding, S.J. The PH-Controlled Nanoparticles Size of Polydopamine for Anti-Cancer Drug Delivery. J. Mater. Sci. Mater. Med. 2013, 24, 2381–2390. [Google Scholar] [CrossRef]
- Khabir, Z.; Holmes, A.M.; Lai, Y.-J.; Liang, L.; Deva, A.; Polikarpov, M.A.; Roberts, M.S.; Zvyagin, A.V. Human Epidermal Zinc Concentrations after Topical Application of ZnO Nanoparticles in Sunscreens. Int. J. Mol. Sci. 2021, 22, 12372. [Google Scholar] [CrossRef]
- Yazdi, M.K.; Zare, M.; Khodadadi, A.; Seidi, F.; Sajadi, S.M.; Zarrintaj, P.; Arefi, A.; Saeb, M.R.; Mozafari, M. Polydopamine Biomaterials for Skin Regeneration. ACS Biomater. Sci. Eng. 2022, 8, 2196–2219. [Google Scholar] [CrossRef]
- Nguyen, T.N.; Do, Q.H.; Vu, T.T.D.; Nguyen, T.T.; Nguyen, D.T.; Nguyen, T.B.N.; Tran, T.T.H.; Vu, T.K.O.; Nghiem, T.H.L.; Hoa, T.M.T.; et al. Enhancement of Antibacterial Activity by a Copper(II) and Zinc(II) in Chelation with Ethylenediaminetetra-Acetic Acid and Urea Complex. Chem. Pap. 2022, 76, 7163–7176. [Google Scholar] [CrossRef]
- Khalid, A.; Ahmad, P.; Alharthi, A.I.; Muhammad, S.; Khandaker, M.U.; Faruque, M.R.I.; Din, I.U.; Alotaibi, M.A.; Khan, A. Synergistic Effects of Cu-Doped ZnO Nanoantibiotic against Gram-Positive Bacterial Strains. PLoS ONE 2021, 16, e0251082. [Google Scholar] [CrossRef]
- Mengistu, A.; Naimuddin, M.; Abebe, B. Optically Amended Biosynthesized Crystalline Copper-Doped ZnO for Enhanced Antibacterial Activity. RSC Adv. 2023, 13, 24835–24845. [Google Scholar] [CrossRef] [PubMed]
- Guan, G.; Zhang, L.; Zhu, J.; Wu, H.; Li, W.; Sun, Q. Antibacterial Properties and Mechanism of Biopolymer-Based Films Functionalized by CuO/ZnO Nanoparticles against Escherichia Coli and Staphylococcus Aureus. J. Hazard. Mater. 2021, 402, 123542–123556. [Google Scholar] [CrossRef] [PubMed]
- Alavi, M.; Varma, R.S.; PAlavi, M.; Varma, R.S. Phytosynthesis and Modification of Metal and Metal Oxide Nanoparticles/Nanocomposites for Antibacterial and Anticancer Activities: Recent Advances. Sustain. Chem. Pharm. 2021, 21, 100412–100423. [Google Scholar] [CrossRef]
- Liu, M.; Liu, R.; Yu, T.; Shao, W.; Yuan, W.; Lu, J. Enhancement of Antibacterial Activity in CuO/ZnO Nanohybrid p-n Heterojunctions. Mater. Lett. 2024, 356, 135596–135599. [Google Scholar] [CrossRef]
- Nguyen, T.T.T.; Nguyen, Y.N.N.; Tran, X.T.; Nguyen, T.T.T.; Tran, T. Van Green Synthesis of CuO, ZnO and CuO/ZnO Nanoparticles Using Annona Glabra Leaf Extract for Antioxidant, Antibacterial and Photocatalytic Activities. J. Environ. Chem. Eng. 2023, 11, 111003–111016. [Google Scholar] [CrossRef]
- Kong, J.; Zhang, S.; Shen, M.; Zhang, J.; Yoganathan, S. Evaluation of Copper(I)-Doped Zinc Oxide Composite Nanoparticles on Both Gram-Negative and Gram-Positive Bacteria. Colloids Surf. A Physicochem. Eng. Asp. 2022, 643, 128742–128753. [Google Scholar] [CrossRef]
- Hassan, I.A.; Sathasivam, S.; Nair, S.P.; Carmalt, C.J. Antimicrobial Properties of Copper-Doped ZnO Coatings under Darkness and White Light Illumination. ACS Omega 2017, 2, 4556–4562. [Google Scholar] [CrossRef]
- Lupacchini, M.; Mascitti, A.; Giachi, G.; Tonucci, L.; d’Alessandro, N.; Martinez, J.; Colacino, E. Sonochemistry in Non-Conventional, Green Solvents or Solvent-Free Reactions. Tetrahedron 2017, 73, 609–653. [Google Scholar] [CrossRef]
- Morsella, M.; Giammatteo, M.; Arrizza, L.; Tonucci, L.; Bressan, M.; D’Alessandro, N. Lignin Coating to Quench Photocatalytic Activity of Titanium Dioxide Nanoparticles for Potential Skin Care Applications. RSC Adv. 2015, 5, 57453–57461. [Google Scholar] [CrossRef]
- Ghule, K.; Ghule, A.V.; Chen, B.J.; Ling, Y.C. Preparation and Characterization of ZnO Nanoparticles Coated Paper and Its Antibacterial Activity Study. Green Chem. 2006, 8, 1034–1041. [Google Scholar] [CrossRef]
- Chong, C.L.; Fang, C.M.; Pung, S.Y.; Ong, C.E.; Pung, Y.F.; Kong, C.; Pan, Y. Current Updates on the In Vivo Assessment of Zinc Oxide Nanoparticles Toxicity Using Animal Models. BioNanoScience 2021, 11, 590–620. [Google Scholar] [CrossRef]
- Sajjad, H.; Sajjad, A.; Haya, R.T.; Khan, M.M.; Zia, M. Copper Oxide Nanoparticles: In Vitro and in Vivo Toxicity, Mechanisms of Action and Factors Influencing Their Toxicology. Comp. Biochem. Physiol. Part C Toxicol. Pharmacol. 2023, 271, 109682–109702. [Google Scholar] [CrossRef] [PubMed]
- Deokar, A.R.; Perelshtein, I.; Saibene, M.; Perkas, N.; Mantecca, P.; Nitzan, Y.; Gedanken, A. Antibacterial and in Vivo Studies of a Green, One-Pot Preparation of Copper/Zinc Oxide Nanoparticle-Coated Bandages. Membranes 2021, 11, 462. [Google Scholar] [CrossRef] [PubMed]
- Hong, S.; Wang, Y.; Park, S.Y.; Lee, H. Progressive Fuzzy Cation- Assembly of Biological Catecholamines. Sci. Adv. 2018, 4, eaat7457. [Google Scholar] [CrossRef] [PubMed]
- Zhang, G.; Cheng, R.; Yan, J.; Xiao, Y.; Zang, C.; Zhang, Y. Photodegradation Property and Antimicrobial Activity of Zinc Oxide Nanorod-Coated Polypropylene Nonwoven Fabric. Polym. Test. 2021, 100, 107235–107242. [Google Scholar] [CrossRef]
- Tian, G.; Huang, Z.; Wang, H.; Cui, C.; Zhang, Y. Polycaprolactone Nanofiber Membrane Modified with Halloysite and ZnO for Anti-Bacterial and Air Filtration. Appl. Clay Sci. 2022, 223, 106512–106521. [Google Scholar] [CrossRef]
- Jeong, S.; Oh, S.-G. Antiacne Effects of PVA/ZnO Composite Nanofibers Crosslinked by Citric Acid for Facial Sheet Masks. Int. J. Polym. Sci. 2022, 2022, 4694921. [Google Scholar] [CrossRef]
- Coccia, F.; Tonucci, L.; Del Boccio, P.; Caporali, S.; Hollmann, F.; D’Alessandro, N. Stereoselective Double Reduction of 3-Methyl-2-Cyclohexenone, by Use of Palladium and Platinum Nanoparticles, in Tandem with Alcohol Dehydrogenase. Nanomaterials 2018, 8, 853. [Google Scholar] [CrossRef]
- Tonucci, L.; Mascitti, A.; Ferretti, A.M.; Coccia, F.; D’Alessandro, N. The Role of Nanoparticle Catalysis in the Nylon Production. Catalysts 2022, 12, 1206. [Google Scholar] [CrossRef]
- Yeroslavsky, G.; Lavi, R.; Alishaev, A.; Rahimipour, S. Sonochemically-Produced Metal-Containing Polydopamine Nanoparticles and Their Antibacterial and Antibiofilm Activity. Langmuir 2016, 32, 5201–5212. [Google Scholar] [CrossRef]
- Shamhari, N.M.; Wee, B.S.; Chin, S.F.; Kok, K.Y. Synthesis and Characterization of Zinc Oxide Nanoparticles with Small Particle Size Distribution. Acta Chim. Slov. 2018, 65, 578–585. [Google Scholar] [CrossRef] [PubMed]
- Du, D.X.; Anh, P.T.G. Preparation of Cuprous Oxide Nanoparticles Using Ascorbic Acid as a Reducing Agent and Its Photocatalytic Activity. Hue Univ. J. Sci. Nat. Sci. 2019, 128, 31–37. [Google Scholar] [CrossRef]
- Sotoma, S.; Harada, Y. Polydopamine Coating as a Scaffold for Ring-Opening Chemistry to Functionalize Gold Nanoparticles. Langmuir 2019, 35, 8357–8362. [Google Scholar] [CrossRef] [PubMed]






| Sample | Components | Cu (% w/w) | Zn (% w/w) |
|---|---|---|---|
| A | Cu2O/PDA | 20.57 | 0.00 |
| B | CuO/ZnO | 0.68 | 17.20 |
| C | Cu2O/ZnO/PDA | 0.18 | 2.86 |
| D | ZnO | 0.00 | 23.80 |
| E | Cu2O | 19.70 | 0.00 |
| F | ZnO/PDA | 0.00 | 2.60 |
| Blk | --- | 0.00 | 0.00 |
| Sample | Plate–Top View with Disc | Plate–Bottom View with Disc | Inhibition Zone (mm) | Plate–Top View without Disc | Growth | Final Assessment |
|---|---|---|---|---|---|---|
| BlK | ![]() | ![]() | 0 | ![]() | Heavy | Insufficient effect |
| Soaked-FM | ![]() | ![]() | 0 | ![]() | Heavy | Insufficient effect |
| A | ![]() | ![]() | 0 | ![]() | Heavy | Insufficient effect |
| B | ![]() | ![]() | >1 | ![]() | None | Good |
| C | ![]() | ![]() | >1 | ![]() | None | Good |
| D | ![]() | ![]() | >1 | ![]() | None | Good |
| E | ![]() | ![]() | 0–1 | ![]() | Slight to moderate | Limited efficacy |
| F | ![]() | ![]() | 0–1 | ![]() | Slight to moderate | Limited efficacy |
| G | ![]() | ![]() | 0 | ![]() | Heavy | Insufficient effect |
| Sample | Plate–Top View with Disc | Plate–Bottom View with Disc | Inhibition Zone (mm) | Plate–Top View without Disc | Growth | Final Assessment |
|---|---|---|---|---|---|---|
| Blk | ![]() | ![]() | 0 | ![]() | Heavy | Insufficient effect |
| Soaked-FM | ![]() | ![]() | 0 | ![]() | Heavy | Insufficient effect |
| A | ![]() | ![]() | 0 | ![]() | Heavy | Insufficient effect |
| B | ![]() | ![]() | >1 | ![]() | None | Good |
| C | ![]() | ![]() | >1 | ![]() | None | Good |
| D | ![]() | ![]() | 0–1 | ![]() | Slight to moderate | Limited efficacy |
| E | ![]() | ![]() | Variable * | ![]() | Variable * | Unclassified * |
| F | ![]() | ![]() | >1 | ![]() | None | Good |
| G | ![]() | ![]() | 0 | ![]() | Heavy | Insufficient effect |
Disclaimer/Publisher’s Note: The statements, opinions and data contained in all publications are solely those of the individual author(s) and contributor(s) and not of MDPI and/or the editor(s). MDPI and/or the editor(s) disclaim responsibility for any injury to people or property resulting from any ideas, methods, instructions or products referred to in the content. |
© 2024 by the authors. Licensee MDPI, Basel, Switzerland. This article is an open access article distributed under the terms and conditions of the Creative Commons Attribution (CC BY) license (https://creativecommons.org/licenses/by/4.0/).
Share and Cite
d’Alessandro, N.; Coccia, F.; Vitali, L.A.; Rastelli, G.; Cinosi, A.; Mascitti, A.; Tonucci, L. Cu-ZnO Embedded in a Polydopamine Shell for the Generation of Antibacterial Surgical Face Masks. Molecules 2024, 29, 4512. https://doi.org/10.3390/molecules29184512
d’Alessandro N, Coccia F, Vitali LA, Rastelli G, Cinosi A, Mascitti A, Tonucci L. Cu-ZnO Embedded in a Polydopamine Shell for the Generation of Antibacterial Surgical Face Masks. Molecules. 2024; 29(18):4512. https://doi.org/10.3390/molecules29184512
Chicago/Turabian Styled’Alessandro, Nicola, Francesca Coccia, Luca Agostino Vitali, Giorgia Rastelli, Amedeo Cinosi, Andrea Mascitti, and Lucia Tonucci. 2024. "Cu-ZnO Embedded in a Polydopamine Shell for the Generation of Antibacterial Surgical Face Masks" Molecules 29, no. 18: 4512. https://doi.org/10.3390/molecules29184512
APA Styled’Alessandro, N., Coccia, F., Vitali, L. A., Rastelli, G., Cinosi, A., Mascitti, A., & Tonucci, L. (2024). Cu-ZnO Embedded in a Polydopamine Shell for the Generation of Antibacterial Surgical Face Masks. Molecules, 29(18), 4512. https://doi.org/10.3390/molecules29184512